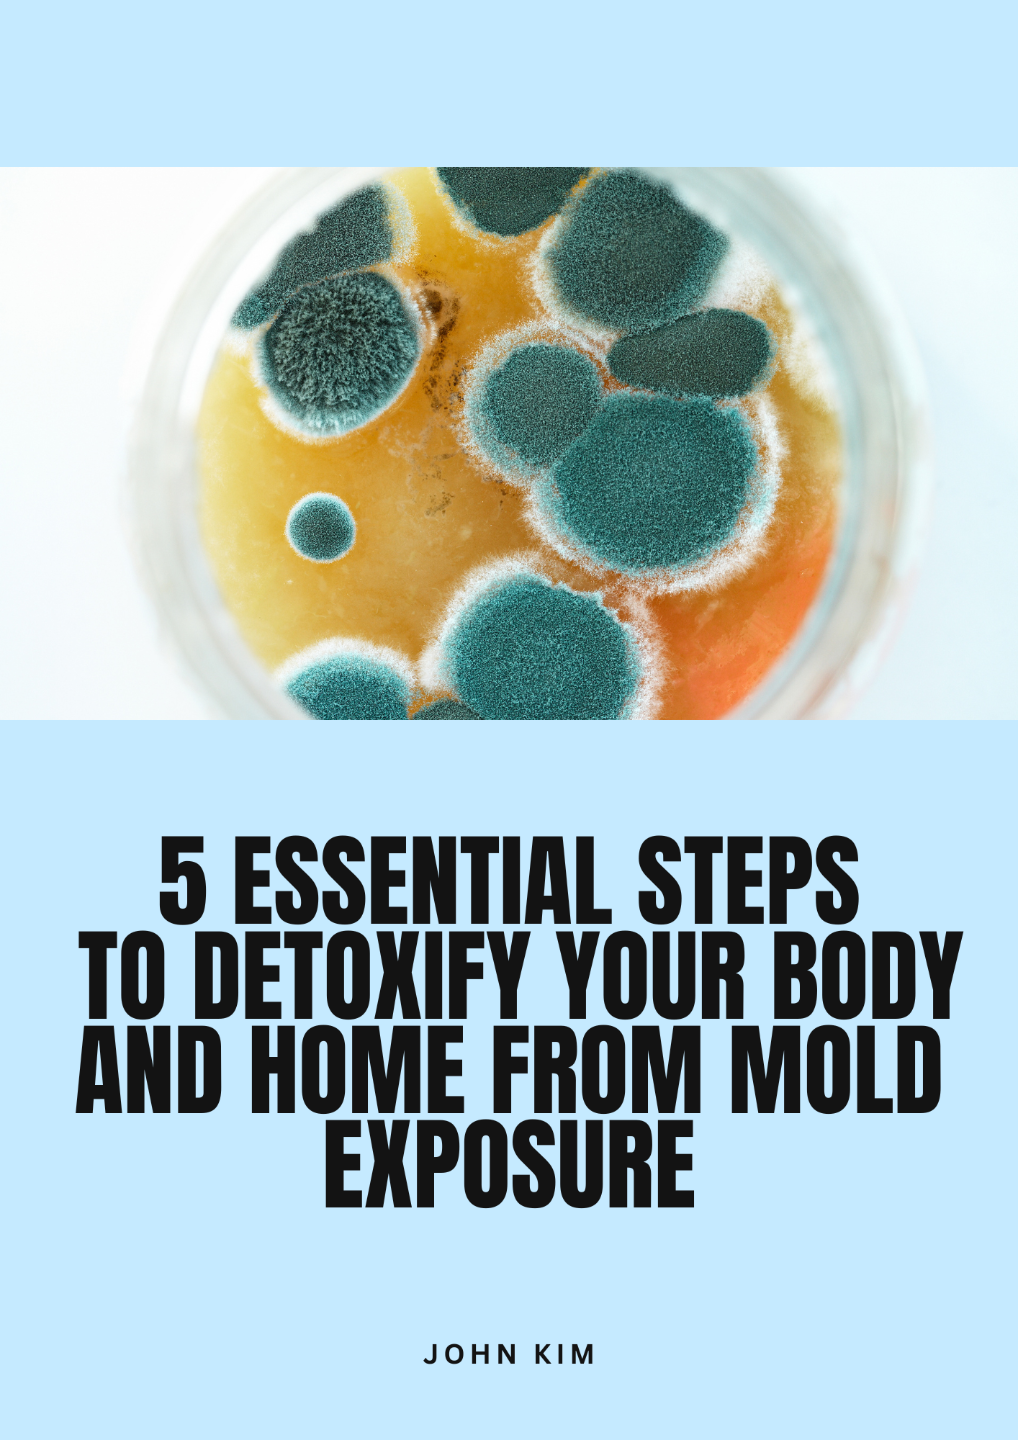

Don’t Miss Out on This Exclusive Offer!
Are you ready to reclaim your health and create a safer home environment?
We won't send spam. Unsubscribe at any time.
Unlock the Path to Better Health with My Free eBook
Imagine living in an environment free from the harmful effects of mold, with your body’s detox pathways fully optimized and your energy levels restored. That’s exactly what you’ll achieve with the insights provided in this comprehensive guide.
What You’ll Receive:
 • Clear, Actionable Steps:Â
 • Practical Tips and Resources:Â
 • Scientific Insights Explained:Â
 • A Roadmap to a Healthier Home:Â
How You Can Utilize This Value:
 • Start Your Detox Journey:Â
 • Implement Home Improvements:Â
 • Enhance Your Health Knowledge:Â
This eBook isn’t just for you—it’s for anyone who may be suffering from the effects of mold toxicity. Share it with friends, family, or colleagues who could benefit from this valuable information, and connect with a community that’s focused on holistic health.